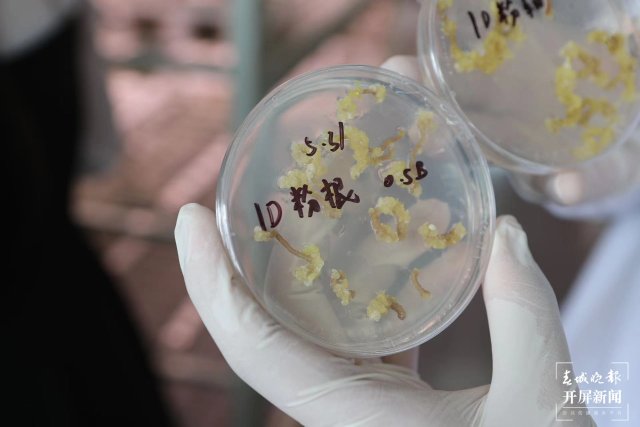

洋桔梗在云南花卉产业中占据重要地位,但其商业种子被国外公司垄断。为攻破洋桔梗种业“卡脖子”问题,让“种子芯片”掌握在云南人自己手里,日前,云南省农业科学院花卉研究所的科研团队通过多年研究,在洋桔梗“人工种子”培育方面有了重大突破。

“洋桔梗,育种条件非常高。”在昆明市呈贡区国际花卉技术创新中心里,国家观赏园艺工程技术研究中心共享实验室李帆博士分享了这一创新技术。他告诉记者,长期以来,日本公司垄断着洋桔梗商业种子。洋桔梗种子虽然比芝麻还小,但市场价高达0.6元一粒,按照其0.05g的千粒重计算,一克种子约1.2万元,是黄金价格的30倍,堪比种子中的“钻石”。
云南省农业科学院花卉研究所以“国家观赏园艺工程技术研究中心”为基础,在呈贡斗南建设了“国际花卉技术创新中心”这一创新平台,为的就是通过科研攻关,支撑“云花”产业的发展,为“云花”高质量发展提供品种和技术支持,让产业不再依赖于国外品种,把“种子芯片”掌握在云南人自己手中。
科研团队攻下的一大难题正是洋桔梗人工种子的研发,解决了洋桔梗种业“卡脖子”问题。李帆介绍,科研团队经过对多种商业品种体细胞胚的诱导筛选,成功研发出能高效诱导体细胞胚形成的组培体系。通过该组培体系,1L培养基中可产生10万个胚体,即10万粒种子。这些胚状体通过后期培育和人工包衣后就成了和自然种子无异的人工种子。人工种子具有生产成本低、繁殖速度快、不受季节限制、保持品种优良遗传性状等特点。得益于此次研究成果,洋桔梗人工种子的应用将解决洋桔梗种苗高效繁育问题。

除了洋桔梗外,科研团队正在加快自主花卉新品种的研发,力争在3到5年内,解决蓝色花卉新品种培育问题,力争10至20年内,让滇丁香、绿绒蒿等云南特色花卉从“野花”成为具有商业价值的商业品种,从野外走向市场、走进千家万户。